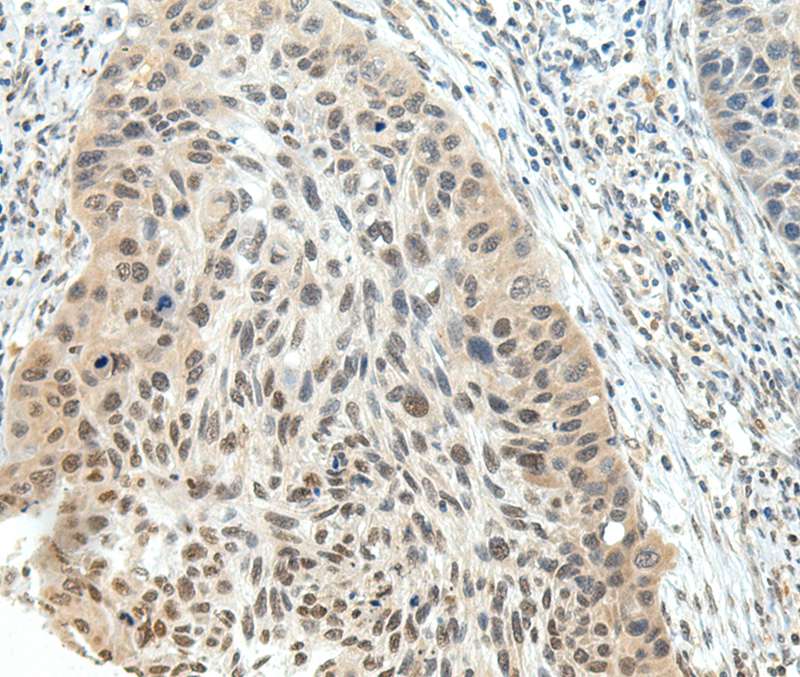

NSD1 Antibody
LS-C813061
ApplicationsWestern Blot
Product group Antibodies
TargetNSD1
Overview
- SupplierLifeSpan BioSciences
- Product NameNSD1 Antibody
- Delivery Days Customer23
- Application Supplier NoteApplications should be user optimized.
- ApplicationsWestern Blot
- Applications SupplierWB (1:1000 - 1:2000) Applications should be user optimized.
- CertificationResearch Use Only
- ClonalityMonoclonal
- ConjugateUnconjugated
- Estimated Purity...
- Gene ID64324
- Target nameNSD1
- Target descriptionnuclear receptor binding SET domain protein 1
- Target synonymsandrogen receptor coactivator 267 kDa protein; androgen receptor-associated coregulator 267; androgen receptor-associated protein of 267 kDa; ARA267; H3-K36-HMTase; H4-K20-HMTase; histone-lysine N-methyltransferase, H3 lysine-36 and H4 lysine-20 specific; histone-lysine N-methyltransferase, H3 lysine-36 specific; KMT3B; lysine N-methyltransferase 3B; NR-binding SET domain-containing protein; nuclear receptor SET domain-containing protein 1; nuclear receptor-binding SET domain-containing protein 1; SOTOS; SOTOS1; STO; truncated nuclear receptor binding SET domain protein 1
- HostMouse
- Storage Instruction-20°C
- UNSPSC12352203